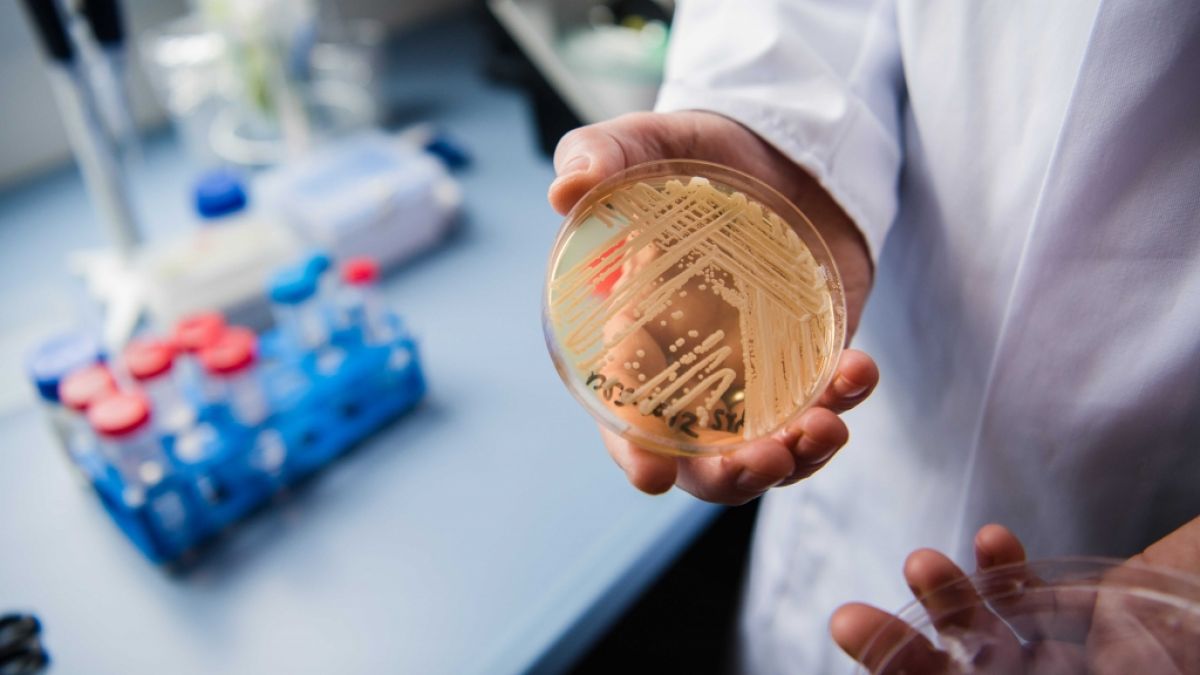
In Deutschland werden immer mehr Infektionen mit dem Hefepilz Candidozyma auris gemeldet. Ein neuer ECDC-Bericht zeigt einen alarmierenden Trends. (Foto)

Medikamente helfen nicht: Tödlicher Erreger breitet sich aus - davor warnen Experten
Ein neuer Bericht des Europäischen Zentrums für die Prävention und Kontrolle von Krankheiten (ECDC) zeigt eine alarmierende Entwicklung. Ein oft in Krankenhäusern vorkommender Hefepilz breitet sich rasend schnell aus - Medikamente wirken kaum.
Erstellt von Ines Fedder - Uhr
Suche
Suche
- Multiresistenter Krankenhauskeim Candida auris breitet sich in Europa rasant aus
- Deutschland auf Platz fünf der gemeldeten Fälle zwischen 2013 und 2023
- Für Gesunde meist harmlos, für Immungeschwächte lebensgefährlich
Der krankheitserregende Pilz Candidozyma auris verbreitet sich rasch in europäischen Krankenhäusern. Das geht aus einem Bericht des Europäischen Zentrums für die Prävention und die Kontrolle von Krankheiten (ECDC) hervor.
Weitere Gesundheitsnews hier:
- HKU5-CoV-2 sorgt aktuell für Rätsel - Experten äußern Besorgnis
- "Dieser Schritt wird Leben kosten" - US-Präsident überrascht mit Kursänderung
Gefährlicher Krankenhauskeim Candidozyma auris breitet sich aus - Deutschland auf Platz 5
Demnach lag Deutschland bei der Anzahl der gemeldeten Fälle zwischen 2013 und 2023 EU-weit auf Platz fünf. Die meisten Fälle wurden in Spanien gemeldet, danach folgten Griechenland, Italien und Rumänien.
Candidozyma auris ist gegen verschiedene Medikamente resistent und kann bei kranken Menschen schwere Infektionen verursachen.
Candidozyma auris auch als Candida auris bekannt: Das macht ihn so gefährlich
Der Hefepilz, der erstmals 2009 in Japan entdeckt wurde, kann auf den verschiedensten Oberflächen überleben. Oft tritt er in Krankenhäusern in Erscheinung, setzt sich dort an medizinischen Geräten fest und wird anschließend durch sogenannte Schmierinfektionen von Mensch zu Mensch übertragen. Wie der Name schon sagt, werden die Krankheitserreger hier durch verschmierte Oberflächen weitergegeben. Laut Expert:innen sei es so besonders schwer, eine Ausbreitung der Keime zu unterbinden oder zu kontrollieren.
Für gesunde Menschen ist eine Infektion mit Candidozyma auris in der Regel nicht gefährlich. Da sich der Keim jedoch vermehrt in Krankenhäusern ausbreitet, wo die Patient:innen in der Regel mit gesundheitlichen Problemen zu kämpfen haben, gilt eine Infektion hier als gewichtiges Problem. Patient:innen mit geschwächtem Immunsystem erleiden durch die Pilzinfektion im schlimmsten Fall eine sogenannte Sepsis (Blutvergiftung).
Candida auris nur schwer behandelbar: Warum helfen keine Medikamente?
Bereits vor über drei Jahren warnte die Universität Würzburg vor einem deutlichen Anstieg der Fallzahlen. Gegenüber "RTL" erklärte Mediziner Dr. Christoph Specht bezüglich einer möglichen Behandlung: Eine Infektion mit dem Keim sei deshalb so problematisch, weil "Antimykotika (Pilzmittel), die normalerweise zur Behandlung von Candida-Infektionen einsetzt werden, wirkungslos sind".
Symptome: Wie äußerst sich eine Infektion mit dem multiresistenten Krankenhauskeim?
VirologeProf. Dr. Hendrik Streeck erklärt gegenüber RTL auch, welche möglichen Anzeichen sich bei einem Candidozyma auris-Befall bemerkbar machen: Zunächst einmal zeige sich nichts Besonderes, abgesehen von einer Rötung, so der Mediziner. Gefährlich wird es, wenn der Pilz bei immungeschwächten Personen ins Blut eindringt. Bei einer sogenannten Fungämie, Pilzinfektion im Blut, werden verschiedene Organe wie Niere, Leber oder Gehirn befallen - eine Blutvergiftung droht.
Zahlen nur die Spitze des Eisbergs
Das ECDC (Europäische Zentrum für die Prävention und Kontrolle von Krankheiten) schreibt in dem aktuellen Bericht, die Zahlen seinen nur "die Spitze des Eisberges". In vielen Ländern werden Infektionen gar nicht erst erfasst. Von 2013 bis 2023 wurden im europäischen Wirtschaftsraum mehr als 4.000 Fälle registriert - 1.346 davon allein im Jahr 2023. Deutschland meldete insgesamt 120 Fälle.
Experten alarmiert, aber nicht beunruhigt
Und obwohl der Bericht zeigt, dass man hier unbedingt wachsam sein sollte, gibt es auch Entwarnung. Oliver Kurzai, Leiter des Instituts für Hygiene und Mikrobiologie an der Julius-Maximilians-Universität Würzburg erklärte gegenüber der "Tagesschau": ""Es macht uns Sorgen aus epidemiologischer Sicht, aber für den einzelnen individuellen Patienten ist die Wahrscheinlichkeit, damit in Kontakt zu kommen, niedrig", so der Experte.
Folgen Sie News.de schon bei WhatsApp, Facebook, Twitter, Pinterest und YouTube? Hier finden Sie brandheiße News, aktuelle Videos und den direkten Draht zur Redaktion.
ife/dpa/mlk/news.de
Erfahren Sie hier mehr über die journalistischen Standards und die Redaktion von news.de.